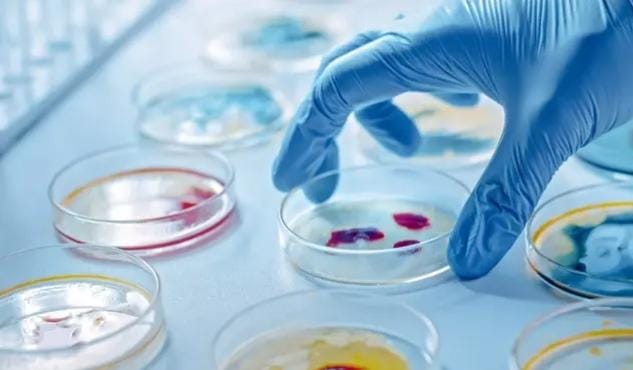

Reseña Histórica:
El Centro de Biotecnología fue creado el 15 de febrero de 1995 como el Programa de Biotecnología perteneciente al Departamento de Química y con la incorporación del Departamento de Biología e Industrias, todos ellos en la Facultad de Ciencias y Tecnología de la Universidad Mayor de San Simón en Cochabamba -Bolivia.
El CBT es una unidad de investigación que se dedica principalmente a actividades de investigación en el estudio de la biodiversidad microbiana y sus potenciales aplicaciones en biotecnología teniendo en cuenta que en Bolivia se cuenta con una enorme biodiversidad microbiana que debe de ser estudiada y explotada sosteniblemente.
Misión:
Promover una adecuada conservación de la biodiversidad microbiana en Bolivia y estudiar sus potenciales aplicaciones biotecnológicas teniendo como base una investigación desarrollada con seguridad, innovación, precisión y responsabilidad.
Visión:
Ser un centro de investigación de excelencia en la generación e innovación en procesos biotecnológicos, logrando el liderazgo en investigación científica tanto a nivel departamental, nacional e internacional.
Objetivos:
Investigar, desarrollar, adecuar proyectos y nuevas técnicas de producción biotecnológica, formando personal altamente capacitado en el área de la biotecnología. Esta investigación y los proyectos deben de estar ligados de igual manera a las necesidades tanto regionales como nacionales los cuales deben resolver problemas de impacto socioeconómico y ambiental que puedan ser resueltos mediante la aplicación de técnicas biotecnológico.
| APARTADO DE VIDEOS
| APARTADO DE IMAGENES

INTA Costa Rica
Sistema autotróficos hidrófono (SAH) en raíces y tubérculos como técnica de propagación masiva.
Se hizo una demostración de como INTA Costa Rica ha adaptado con éxito la técnica SAH al proceso de aclimatación de plantas in vitro de yuca.
Frontiers in Microbilogy
La investigación realizada por el equipo , revela el descubrimiento de la microorganismo con capacidades extraordinarias : la bacteria Bacillus safensis VC- 6 . Aislada de las condiciones extremas de la region volcánica de Copahue.

Centro de Biotecnologia y Nanotecnologia de la UMSS
Participa en el Congreso de Quinua realizada en China .
El tema que presenta es la tropicalización de la Quinua Boliviana.
| CONTÁCTENOS
TELÉFONO
4 4542895
cbt-fcyt@umss.edu.bo


